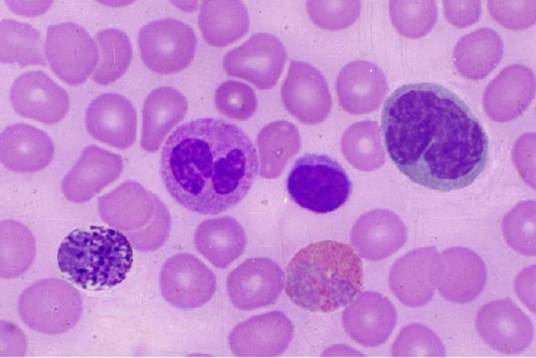
淋巴细胞

淋巴细胞
的有关信息介绍如下:
淋巴细胞(lymphocyte)是白细胞的一种,是体积最小的白细胞。其由淋巴器官产生,主要存在于淋巴管中循环的淋巴液中,是机体免疫应答功能的重要细胞成分,是淋巴系统几乎全部免疫功能的主要执行者,是对抗外界感染和监控体内细胞变异的一线“士兵”。淋巴细胞是一类具有免疫识别功能的细胞系,按其发生迁移、表面分子和功能的不同,可分为T淋巴细胞(又名T细胞)、B淋巴细胞(又名B细胞)和自然杀伤(NK)细胞。T细胞和B细胞都是抗原特异性淋巴细胞,它们的最初来源是相同的,都来自造血组织 。
想要了解更多“淋巴细胞”的信息,请点击:淋巴细胞百科



